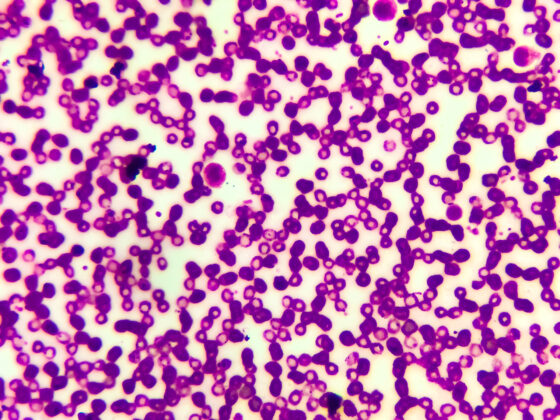

Chronischer Pruritus kann in jedem Lebensalter auftreten und unterschiedliche Patientengruppen betreffen. Um die Ursache zu eruieren und die Betroffenen einer bestmöglichen Behandlung zuzuführen, ist ein leitlinienorientiertes Vorgehen ratsam. Die Therapielandschaft ist im Wandel – davon zeugen unter anderem die in jüngerer Vergangenheit neu zugelassenen Medikamente für die Indikationsbereiche des nephrogenen Pruritus und der Prurigo nodularis.
Autoren
- Mirjam Peter, M.Sc.
Publikation
- DERMATOLOGIE PRAXIS
Related Topics
Dir könnte auch gefallen
- Vom Symptom zur Diagnose
Pneumologie – Covid-19: ein Rückblick
- Altersbedingte neurokognitive Störungen
Neuroprotektive Wirkungen des Ginkgo-biloba-Extrakts
Wie Herkunft und Wohnort den CF-assoziierten Diabetes fördern
- Pankreaskarzinom
Innovative Früherkennung mit Fokus auf Liquid Biopsy und KI
- Vom Symptom zur Diagnose
Abdominalschmerz – Prostataabszess
- Asthma in der Schwangerschaft
Bis zu 40% erleiden Symptomverschlechterung während der Gravidität
- Vom Symptom zur Diagnose
Komplizierte Nierenzysten
- Schweres Asthma und CRSwNP